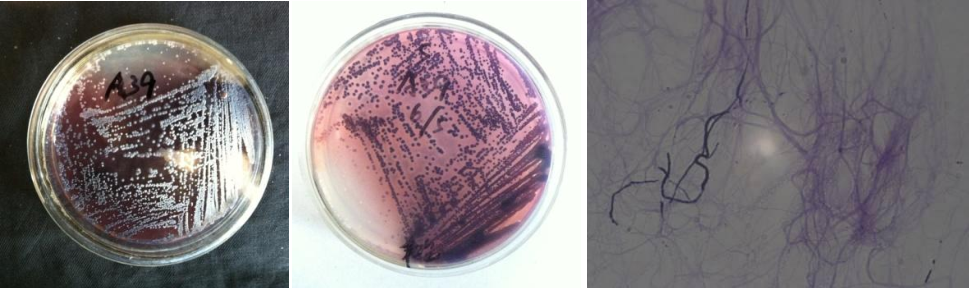

Loading...
| StrainNO | A39 |
| Classification | Streptomyces |
| 16s rDNA sequence | GACGAACGCTGGCGGCGTGCTTAACACATGCAAGTCGAACGGTGAAGCCTTTTGGGGTGGATCAGTGGCGAACGGGTGAGTAAC ACGTGGCAATCTGCCCTGCACTCTGGGATAAGCCTTGGAAACGGGGTCTAATACCGGATATGACATGGGAGCGCATGTTTCTGT GTGGAAAGTTTCGGCGGTGTAGGATGAGCTCGCGGCCTATCAGCTTGTTGGTGGGGTGATGGCCTACCAAGGCGACGACGGGTA GCCGGCCTGAGAGGGCGATCGGCCACACTGGGACTGAGACACGGCCCAGACTCCTACGGGAGGCAGCAGTGGGGAATATTGCAC AATGGGCGAAAGCCTGATGCAGCGACGCCGCGTGGGGGATGACGGCCTTCGGGTTGTAAACCTCTTTCAGCAGGGAAGAAGCCT TTGGGTGACGGTACTTGCAGAAGAAGCACCGGCTAACTACGTGCCAGCAGCCGCGGTAATACGTAGGGTGCGAGCGTTGTCCGG AATTATTGGGCGTAAAGAGCTCGTAGGCGGCTTGTTGCGTCGGATGTGAAAGCCCGGGGCTTAACCTCGGGTCTGCATTCGATA CGGGCAGGCTGGAGTTCGGTAGGGGAGATCGGAATTCCTGGTGTAGCGGTGAAATGCGCAGATATCAGGAGGAACACCGGTGGC GAAGGCGGATCTNTGNGCCGATACTGACGCTGAGGAGCGAAAGCGTGGGGAGCGAACAGGATTAGATACCCTGGTAGTCCACGC CGTAAACGTTGGGAACTAGGTGTGGGCTGCATTCCACGTGGTCCGTGCCGTAGCTAACGCATTAAGTTCCCCGCCTGGGGAGTA CGGCCGCAAGGCTAAAACTCAAAGGAATTGACGGGGGCCCGCACAAGCAGCGGAGCATGTGGCTTAATTCGACGCAACGCGAAG AACCTTACCAAGGCTCGACATGCATCGGAAGCGGTCGGAGACGGTCGTGCCCTTGTGGTCGGTGTACAGGTGGTGCATGGCTGT CGTCAGCTCGTGTCGTGAGATGTTGGGTTAAGTCCCGCAACGAGCGCAACCCTTGTCTCGTGTTGCCAGCAGGCCTTTGTGGTG CTGGGGACTCACGGGAGACCGCCGGGGTCAACTCGGAGGAAGGTGGGGACGACGTCAAGTCATCATGCCCCTTATGTCTTGGGC TGCACACGTGCTACAATGGCTGGTACAATGAGTTGCGATGCCGTGAGGTGGAGCGAATCTCAAAAAGCCGGTCTCAGTTCGGAT TGGGGTCTGCAACTCGACCCCATGAAGTCGGAGTTGCTAGTAATCGCAGATCAGCAGTGCTGCGGTGAATACGTTCCCGGGCCT TGTACACACCGCCCGTCACGTCACGAAAGTCGGTAACACCCGAAGCCGGTGGCCTAACCTCTTTGTGGGGAGGGAGTCGTCGAA TGGTGGGATCTGGCGATTGGGACG ACGTGGCAATCTGCCCTGCACTCTGGGATAAGCCTTGGAAACGGGGTCTAATACCGGATATGACATGGGAGCGCATGTTTCTGT GTGGAAAGTTTCGGCGGTGTAGGATGAGCTCGCGGCCTATCAGCTTGTTGGTGGGGTGATGGCCTACCAAGGCGACGACGGGTA GCCGGCCTGAGAGGGCGATCGGCCACACTGGGACTGAGACACGGCCCAGACTCCTACGGGAGGCAGCAGTGGGGAATATTGCAC AATGGGCGAAAGCCTGATGCAGCGACGCCGCGTGGGGGATGACGGCCTTCGGGTTGTAAACCTCTTTCAGCAGGGAAGAAGCCT TTGGGTGACGGTACTTGCAGAAGAAGCACCGGCTAACTACGTGCCAGCAGCCGCGGTAATACGTAGGGTGCGAGCGTTGTCCGG AATTATTGGGCGTAAAGAGCTCGTAGGCGGCTTGTTGCGTCGGATGTGAAAGCCCGGGGCTTAACCTCGGGTCTGCATTCGATA CGGGCAGGCTGGAGTTCGGTAGGGGAGATCGGAATTCCTGGTGTAGCGGTGAAATGCGCAGATATCAGGAGGAACACCGGTGGC GAAGGCGGATCTNTGNGCCGATACTGACGCTGAGGAGCGAAAGCGTGGGGAGCGAACAGGATTAGATACCCTGGTAGTCCACGC CGTAAACGTTGGGAACTAGGTGTGGGCTGCATTCCACGTGGTCCGTGCCGTAGCTAACGCATTAAGTTCCCCGCCTGGGGAGTA CGGCCGCAAGGCTAAAACTCAAAGGAATTGACGGGGGCCCGCACAAGCAGCGGAGCATGTGGCTTAATTCGACGCAACGCGAAG AACCTTACCAAGGCTCGACATGCATCGGAAGCGGTCGGAGACGGTCGTGCCCTTGTGGTCGGTGTACAGGTGGTGCATGGCTGT CGTCAGCTCGTGTCGTGAGATGTTGGGTTAAGTCCCGCAACGAGCGCAACCCTTGTCTCGTGTTGCCAGCAGGCCTTTGTGGTG CTGGGGACTCACGGGAGACCGCCGGGGTCAACTCGGAGGAAGGTGGGGACGACGTCAAGTCATCATGCCCCTTATGTCTTGGGC TGCACACGTGCTACAATGGCTGGTACAATGAGTTGCGATGCCGTGAGGTGGAGCGAATCTCAAAAAGCCGGTCTCAGTTCGGAT TGGGGTCTGCAACTCGACCCCATGAAGTCGGAGTTGCTAGTAATCGCAGATCAGCAGTGCTGCGGTGAATACGTTCCCGGGCCT TGTACACACCGCCCGTCACGTCACGAAAGTCGGTAACACCCGAAGCCGGTGGCCTAACCTCTTTGTGGGGAGGGAGTCGTCGAA TGGTGGGATCTGGCGATTGGGACG |
| Strain Morphology Photos | |
| Morphological Description | hyphae branch;flourish;protoplast condensed;spore filaments straight or curved;spore chain long and curved;old mycelium vacuoles in clusters;spore pile dark gray;back light blue |